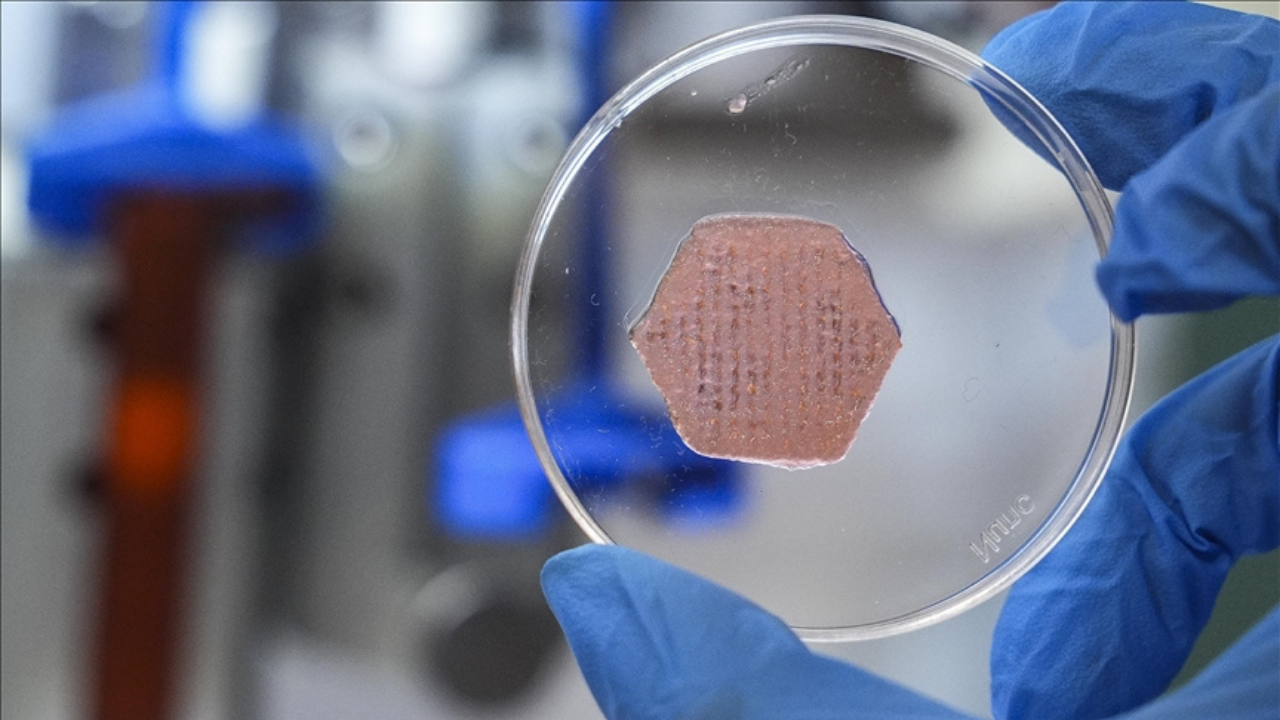

Fen Fakültesi Kimya Bölümü Öğretim Üyesi Seda Kehr ve ekibi tarafından yaklaşık iki yıllık çalışma sonucunda geliştirilen ürün, “Oksijen Taşıyıcı, Esansiyel Yağ ve Probiyotik Metabolitler İçeren Canlı Hidrojel Bazlı Yara Örtüsü” adıyla Türk Patent ve Marka Kurumu tarafından tescillendi.
Klasik yara bantlarından farklı olarak tasarlanan sistemin, probiyotik mikroorganizmaları canlı şekilde bünyesinde barındırdığı ve oksijen salınımı yapabilen nano parçacıklarla desteklendiği belirtildi. Esansiyel yağlarla zenginleştirilen yapı, enfeksiyon riskinin azaltılmasını ve doku iyileşmesinin hızlandırılmasını hedefliyor.
Araştırma ekibi, probiyotikleri çevresel etkilerden korumak için kapsülleme teknolojisi kullandıklarını ve bu sayede faydalı metabolitlerin kontrollü şekilde salınımının sağlandığını açıkladı.
Yeni yara örtüsünün ilk aşamada deri hastalıklarında kullanılmasının planlandığı, ilerleyen klinik süreçlerde ise enjekte edilebilir formuyla vücut içindeki yaralarda da uygulanabileceği ifade edildi. Ürünün püskürtülebilir jel formunda ve üç boyutlu yazıcı teknolojisiyle hastalara özel ölçülerde üretilebileceği de aktarıldı.
Laboratuvar ortamında bakteri ve hücre testleri tamamlanan çalışmanın bir sonraki aşamasında hayvan testleri ve klinik araştırma süreçlerinin başlatılması hedefleniyor. Araştırmanın başarılı olması durumunda, kronik yara tedavilerinde yeni bir yaklaşım sunması bekleniyor.